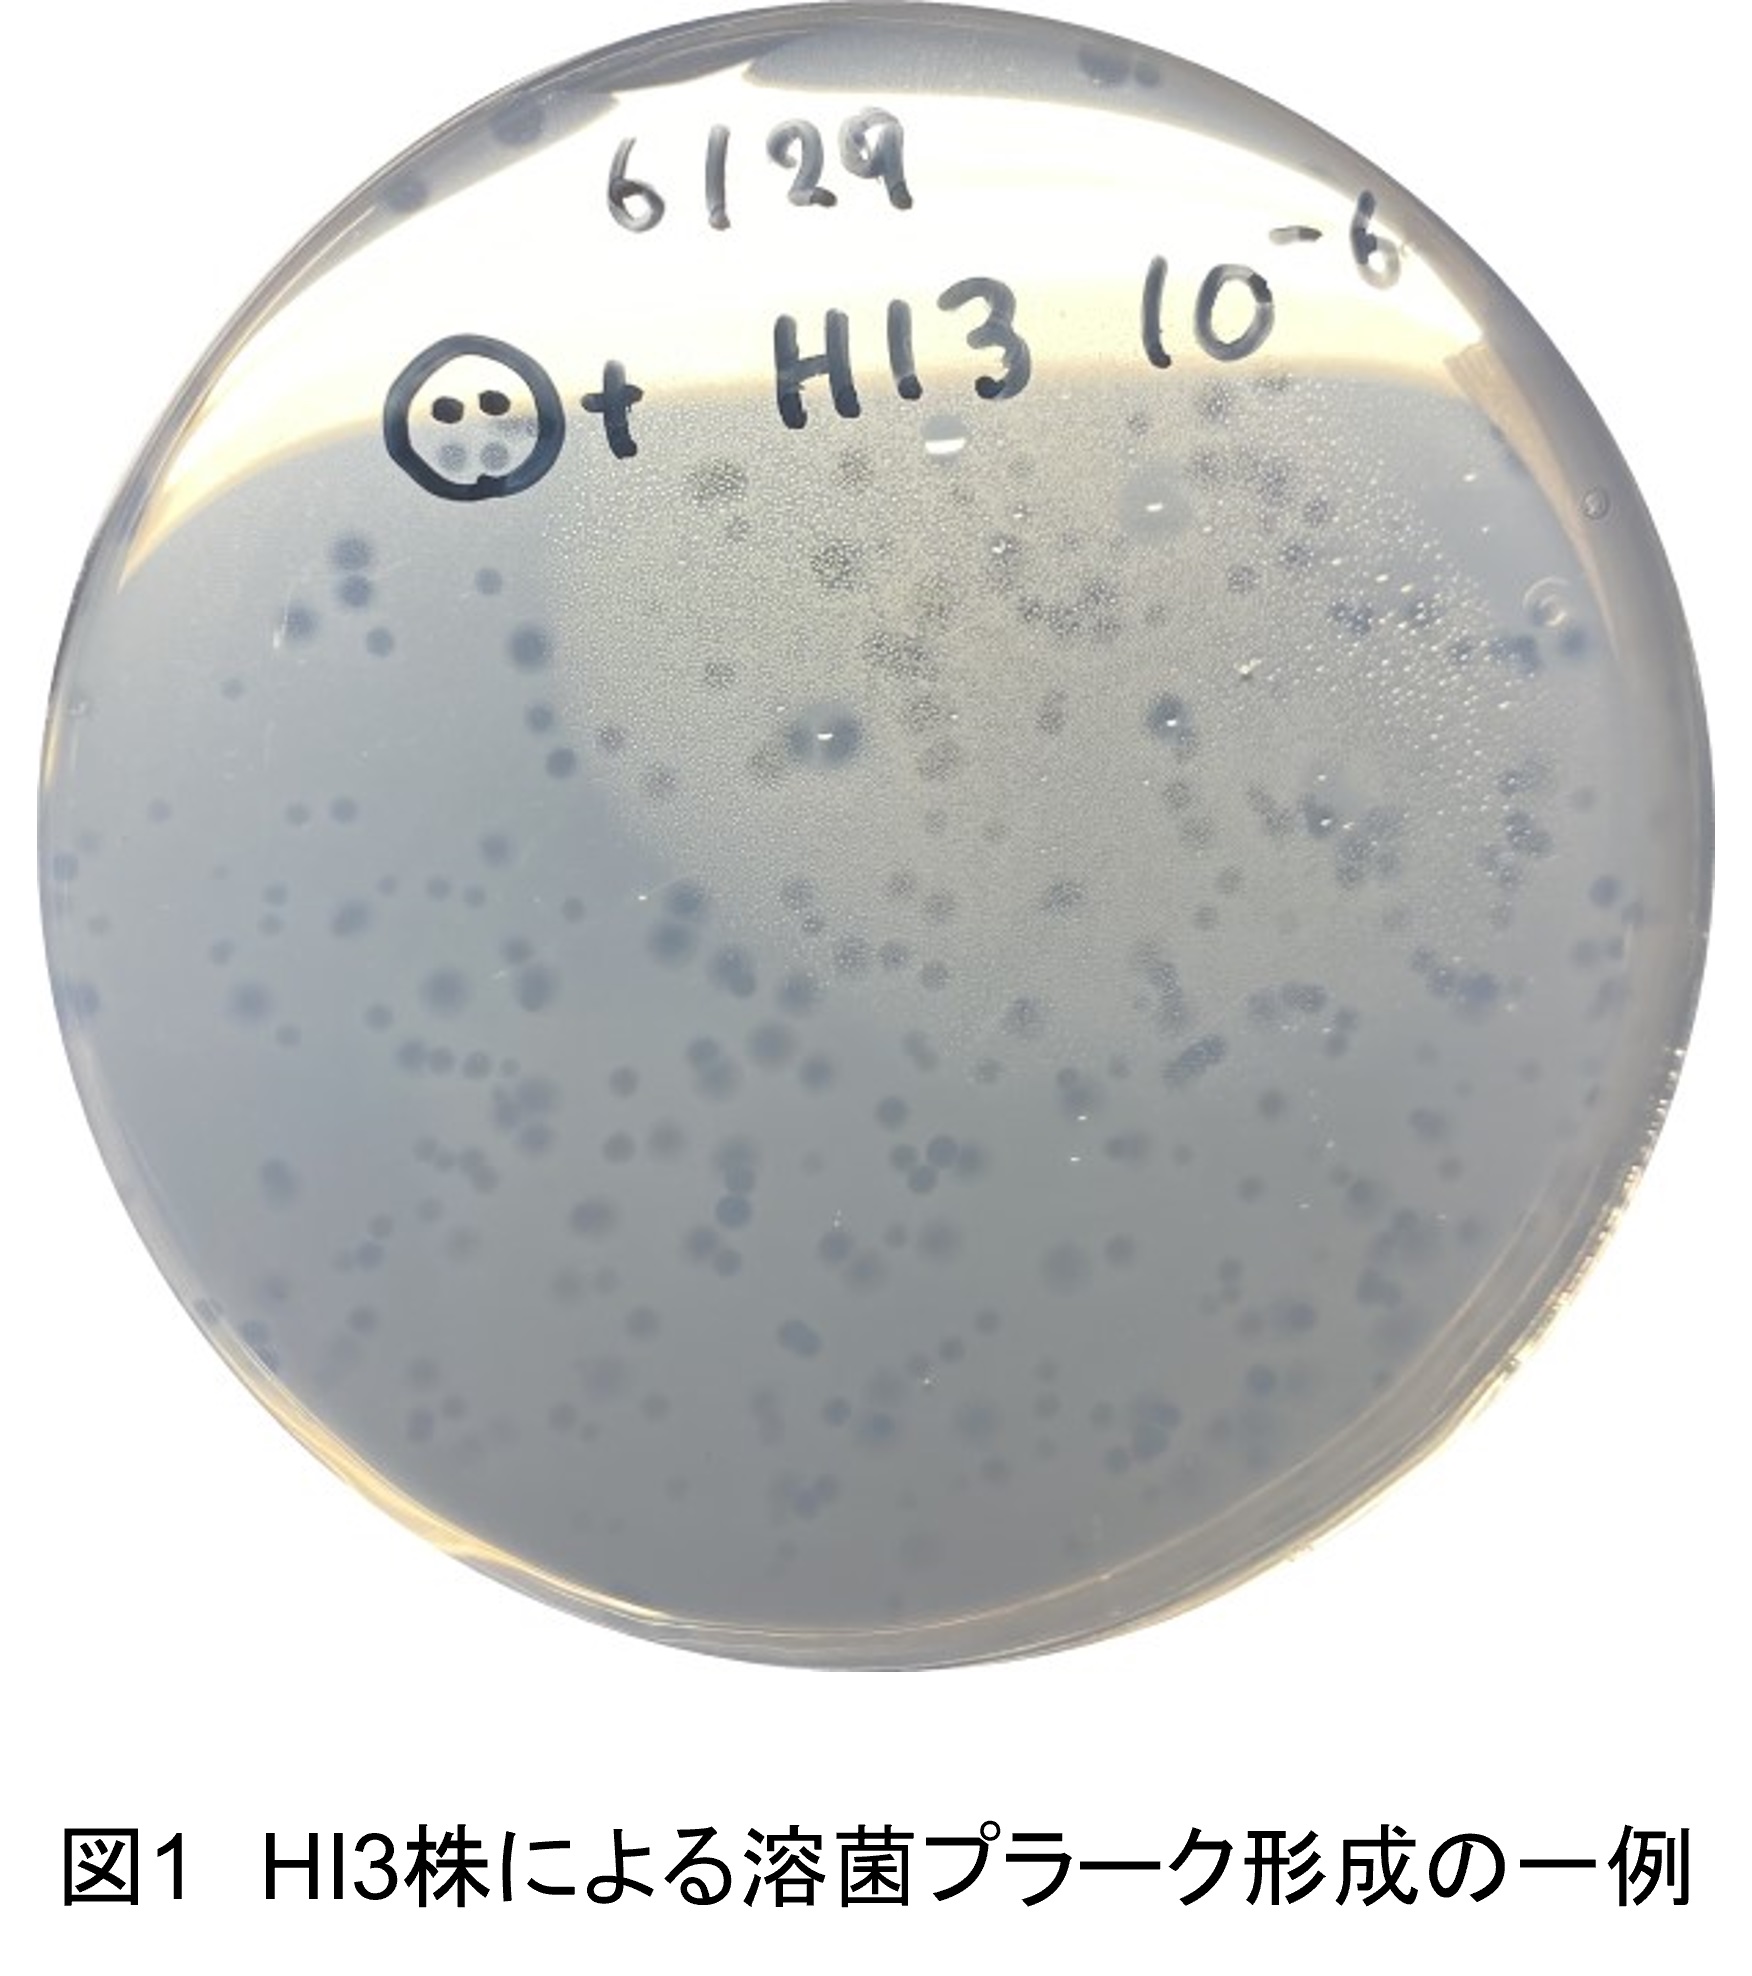
plate

NBRCニュース 第86号

今号の内容
1.
新たにご利用可能となった微生物株
酵母では、千葉県木更津市内の花から分離された新種 Starmerella kisarazuensis を公開しました(NBRC 115909~115910, NBRC 116270)。糸状菌では、日本産のハチミツより分離されたTalaromyces属の好乾性の新種Talaromyces mellisjaponiciとその近縁のTalaromyces affinitatimellis、Talaromyces basipetosporus、Talaromyces speluncarum(NBRC 116043~116051)を公開しました。細菌では、特許第4690972号に記載されているカドミウム除去能を有する菌株Halobacillus truperi FERM P-20976およびStaphylococcus xylosus FERM P-20977をそれぞれNBRC 114266およびNBRC 114267として公開しました。また、オーストラリアのカンガルー島で採取された虫や花に由来するFructilactobacillus属の乳酸菌(NBRC 114983、NBRC 114985~114989)を公開しました。
【新たに提供を開始した微生物資源】
https://www.nite.go.jp/nbrc/cultures/nbrc/new_strain/new_dna.html
2.
微生物あれこれ(62)
循環型社会の形成を目指して ~ケカビ門の可能性~
(森谷 千星)
産業界では、循環型社会の形成を目指して、製造過程での副産物や使い終わった製品を廃棄物ではなく資源として捉え、再利用して素材や製品にまた戻していく新たなものづくりの考え方が求められています。また近年では、石油資源を素材とした物理化学的製造プロセスから、生物を用いた技術で製品をつくる「バイオものづくり」の製造プロセスへの転換が推進され、これまで微生物が利用されてこなかった分野においても、微生物による有用物質生産技術が注目されています。
そこで今回は、糸状菌の中でも非常に多様な代謝産物を産生し、バイオリファイナリーへの貢献が期待されている(1)ケカビ門Mucoromycota(以前は接合菌と呼ばれていた菌群の一部)についてご紹介します。ケカビ門に含まれる菌種には、脂質や色素、キチン/キトサン、ポリリン酸塩、エタノール、有機酸、酵素といった有用物質を産生するものが知られています。その中で本稿では、食品や健康、医療、エネルギーなど幅広い分野で利用される油脂の生産に関するものを紹介します。
「油糧微生物」とは、自身の菌体重量の20%以上の油脂を細胞内に蓄積する微生物のことを言います。ケカビ門では、Absidia、Actinomucor、Backusella、Circinella、Cunninghamella、Gilbertella、Helicostylum、Lichtheimia、Mucor、Mortierella、Rhizomucor、Rhizopus、Syncephalastrum属が知られています(2)。これらの菌は、一価不飽和脂肪酸(パルミトオレイン酸、オレイン酸など)や人体では合成できない多価不飽和脂肪酸(リノール酸:LAやα-リノレン酸:ALA、アラキドン酸:ARA、エイコサペンタエン酸:EPA、ドコサヘキサエン酸:DHAなど)を多量に蓄積します。また、Mucor属はグルコース、Mortierella属はマルトースの資化能が高いなど、属によって高い資化能を示す炭素源が異なることや、炭素源によって蓄積する脂肪酸の種類や量も変わることも分かっています(3)。そのため、原料として用いる廃棄物等の種類に応じて適切な菌種を選択することで、目的とする油脂の生産が可能になると期待されています。また、ケカビ門が産生する油脂の組成は植物油と類似していますが、植物ではなく微生物で生産する主な利点として、季節や気候に左右されないことや生育期間が短いこと、生産条件を制御することができることなどが挙げられます。微生物を用いることで目的とする油脂を安定的に高純度で生産できることが報告されています(4)。
そこで、特に油脂生産に優れているとされる種について、NBRCから提供している菌株をご紹介します。ぜひご利用ください。
○Mucor circinelloides(NBRC保有株13株)
脂質蓄積を研究するモデルとして使われている糸状菌で、必須脂肪酸の一つであるγ-リノレン酸(GLA)を豊富に蓄積する種(5)。
(一例)
○Mortierella alpina(NBRC保有株3株)
乳幼児の発育や発達に重要なアラキドン酸(ARA)を豊富に蓄積することから、アメリカ食品医薬品局(FDA)及び欧州委員会の認証のもと、様々な国で乳児用の粉ミルクに添加するARAの生産に使用されている種(6)。
○Umbelopsis isabellina(NBRC保有株13株)
バイオ燃料の原料となるオレイン酸やパルミチン酸を豊富に蓄積することから、カーボンニュートラルへの貢献が期待されている種(7)。
(一例)
【文献】
(1)Dzurendova et al. (2022). Appl. Microbiol. Biotechnol. 106, 101-115.
(2)Zhao et al. (2022). Bioenerg. Res. 14, 1196-1206.
(3)Demir&Gündes (2020). Biotechnol. Prog. 36, e3050.
(4)Asadi et al. (2015). Crit. Rev. Biotechnol. 35, 94-102.
(5)Fazili et al. (2022). Microb. Cell Fact. 21, 29.
(6)Chang et al. (2022). Biotechnol. Adv. 54, 107794.
(7)Simara et al. (2020). Biocat. Agric. Biotechnol. 30, 101831.
そこで今回は、糸状菌の中でも非常に多様な代謝産物を産生し、バイオリファイナリーへの貢献が期待されている(1)ケカビ門Mucoromycota(以前は接合菌と呼ばれていた菌群の一部)についてご紹介します。ケカビ門に含まれる菌種には、脂質や色素、キチン/キトサン、ポリリン酸塩、エタノール、有機酸、酵素といった有用物質を産生するものが知られています。その中で本稿では、食品や健康、医療、エネルギーなど幅広い分野で利用される油脂の生産に関するものを紹介します。
「油糧微生物」とは、自身の菌体重量の20%以上の油脂を細胞内に蓄積する微生物のことを言います。ケカビ門では、Absidia、Actinomucor、Backusella、Circinella、Cunninghamella、Gilbertella、Helicostylum、Lichtheimia、Mucor、Mortierella、Rhizomucor、Rhizopus、Syncephalastrum属が知られています(2)。これらの菌は、一価不飽和脂肪酸(パルミトオレイン酸、オレイン酸など)や人体では合成できない多価不飽和脂肪酸(リノール酸:LAやα-リノレン酸:ALA、アラキドン酸:ARA、エイコサペンタエン酸:EPA、ドコサヘキサエン酸:DHAなど)を多量に蓄積します。また、Mucor属はグルコース、Mortierella属はマルトースの資化能が高いなど、属によって高い資化能を示す炭素源が異なることや、炭素源によって蓄積する脂肪酸の種類や量も変わることも分かっています(3)。そのため、原料として用いる廃棄物等の種類に応じて適切な菌種を選択することで、目的とする油脂の生産が可能になると期待されています。また、ケカビ門が産生する油脂の組成は植物油と類似していますが、植物ではなく微生物で生産する主な利点として、季節や気候に左右されないことや生育期間が短いこと、生産条件を制御することができることなどが挙げられます。微生物を用いることで目的とする油脂を安定的に高純度で生産できることが報告されています(4)。
そこで、特に油脂生産に優れているとされる種について、NBRCから提供している菌株をご紹介します。ぜひご利用ください。
○Mucor circinelloides(NBRC保有株13株)
脂質蓄積を研究するモデルとして使われている糸状菌で、必須脂肪酸の一つであるγ-リノレン酸(GLA)を豊富に蓄積する種(5)。
(一例)
| NBRC No. | 分離源 | 研究例 |
| 4554 | Kaoliangchiu-moromi | 抗酸化活性物質生産 |
| 4572 | Kaoliangchiu yeast cake | バイオエタノール生産 |
| 5398 | Air | セルラーゼ生産 |
| 6746 | Soil | バイオファイナリー |
○Mortierella alpina(NBRC保有株3株)
乳幼児の発育や発達に重要なアラキドン酸(ARA)を豊富に蓄積することから、アメリカ食品医薬品局(FDA)及び欧州委員会の認証のもと、様々な国で乳児用の粉ミルクに添加するARAの生産に使用されている種(6)。
| NBRC No. | 分離源 | 原産国 |
| 6568 | 不明 | 不明 |
| 32281 | Soil | 中国 |
| 105990 | Soil | 日本 |
○Umbelopsis isabellina(NBRC保有株13株)
バイオ燃料の原料となるオレイン酸やパルミチン酸を豊富に蓄積することから、カーボンニュートラルへの貢献が期待されている種(7)。
(一例)
| NBRC No. | 分離源 | 原産国 | 研究例 |
| 7884 | 不明 | 不明 | 油脂生産(ゲノム解読株) |
| 7873 | Wood | 不明 | |
| 7874 | 不明 | ドイツ | |
| 105998 | Decaying needle | 日本 | |
| 110180 | Pine deadwood | 日本 |
【文献】
(1)Dzurendova et al. (2022). Appl. Microbiol. Biotechnol. 106, 101-115.
(2)Zhao et al. (2022). Bioenerg. Res. 14, 1196-1206.
(3)Demir&Gündes (2020). Biotechnol. Prog. 36, e3050.
(4)Asadi et al. (2015). Crit. Rev. Biotechnol. 35, 94-102.
(5)Fazili et al. (2022). Microb. Cell Fact. 21, 29.
(6)Chang et al. (2022). Biotechnol. Adv. 54, 107794.
(7)Simara et al. (2020). Biocat. Agric. Biotechnol. 30, 101831.
3.
NBRC寄託株のご紹介(2)
他の細菌を食べて生育する偏性捕食性細菌Bacteriovorax sp. HI3株のご紹介
(大阪大学大学院工学研究科 井上 大介)
このたびBacteriovorax sp. HI3株(=NBRC 116486)をNBRCに寄託させていただきました。同菌株が属するBacteriovorax属や、同属と同じく“偏性捕食性”の生育特性をもつ細菌株はNBRCでは初めての寄託ということで、HI3株だけでなく、Bacteriovorax属やその関連細菌を含めて紹介させていただきます。
Bacteriovorax sp. HI3株が属するBacteriovorax属は、以前はDeltaproteobacteria綱に属していましたが、2020年の再分類により、新たに提案されたBdellovibrionota門に含まれることになり(1,2)、現在は同門のBacteriovoracia綱Bacteriovoracales目Bacteriovoracaceae科に属しています。Bacteriovorax属は、同じくBdellovibrionota門Bdellovibrionia綱に属するBdellovibrio属、Micavibrio属、Pseudobdellovibrio属、Bacteriovoracia綱に含まれるPeredibacter属、Halobacteriovorax属とともに、Bdellovibrio and like organisms(BALOs)と総称されています。BALOsの最大の特徴は、“他の生きた細菌を溶菌し、その細胞成分を栄養として生育する偏性捕食性”です。BALOsが初めて発見されたのは60年以上前ですが(3)、2000年頃から世界的に注目が高まり、研究報告が急速に増えています(4)。
なぜBALOsが注目されるようになったのか?それは、BALOsの“他の生きた細菌を溶菌する”性質が、世界的な脅威の一つとなっている多剤耐性菌などの病原菌に対する抗菌剤として医療・衛生分野で役立つ、ということに端を発しています。BALOsの捕食対象はグラム陰性菌に限られており、ヒトや動植物に対しては害がありません。さらに、抗生物質のように簡単には耐性がつかないと言われており、BALOsは捕食対象を死滅させながら、自分自身は増殖することができるため、効果が長続きすることも利点といえます。このような特性から、BALOsは“Living antibiotic”とも称され、その応用に向けた研究開発が進められています。また、農業や畜産業、養殖業における病原菌の防除、食品の貯蔵・加工における腐敗の抑制など、各種産業において細菌に起因する経済損失を低減する用途でも利用が検討されています。他方、BALOsを含む捕食性細菌は淡水・海水、土壌、動物体内、下排水処理系など様々な環境中に存在しており、他の細菌を溶菌し、その細菌由来の炭素・エネルギーを周囲に供給することにより、微生物叢の形成において重要な機能をもっているとも指摘されています(4)。
私がこのような特徴を有するBALOsに興味を本格的に持ち始めたのは6年ほど前のことです。私が所属する研究室では、生物機能を活用した環境保全・浄化技術、資源・エネルギー生産技術の開発に取り組んでおり、16S rRNAアンプリコンシーケンスを用いた活性汚泥やウキクサ-微生物共生系などの細菌叢解析を日常的に行っています。たまたま何かの機会に耳にした捕食性細菌に興味をもち始めていた当時、学生から提出されたウキクサ-微生物共生系の細菌叢解析結果を眺めている折にBALOsが優占しているデータを目の当たりにしました。そこで、PCに保存していた様々なサンプルの解析結果を見返してみると、量的には少ないものの、多くのサンプルにBALOsが存在していることに気付きました。この偶然をきっかけとして、活性汚泥やウキクサ-微生物共生系に関する研究に絡めてBALOsを対象とした研究ができないかと思い、2019年度に本格的にBALOsの研究に着手することになりました。
Bacteriovorax sp. HI3株が属するBacteriovorax属は、以前はDeltaproteobacteria綱に属していましたが、2020年の再分類により、新たに提案されたBdellovibrionota門に含まれることになり(1,2)、現在は同門のBacteriovoracia綱Bacteriovoracales目Bacteriovoracaceae科に属しています。Bacteriovorax属は、同じくBdellovibrionota門Bdellovibrionia綱に属するBdellovibrio属、Micavibrio属、Pseudobdellovibrio属、Bacteriovoracia綱に含まれるPeredibacter属、Halobacteriovorax属とともに、Bdellovibrio and like organisms(BALOs)と総称されています。BALOsの最大の特徴は、“他の生きた細菌を溶菌し、その細胞成分を栄養として生育する偏性捕食性”です。BALOsが初めて発見されたのは60年以上前ですが(3)、2000年頃から世界的に注目が高まり、研究報告が急速に増えています(4)。
なぜBALOsが注目されるようになったのか?それは、BALOsの“他の生きた細菌を溶菌する”性質が、世界的な脅威の一つとなっている多剤耐性菌などの病原菌に対する抗菌剤として医療・衛生分野で役立つ、ということに端を発しています。BALOsの捕食対象はグラム陰性菌に限られており、ヒトや動植物に対しては害がありません。さらに、抗生物質のように簡単には耐性がつかないと言われており、BALOsは捕食対象を死滅させながら、自分自身は増殖することができるため、効果が長続きすることも利点といえます。このような特性から、BALOsは“Living antibiotic”とも称され、その応用に向けた研究開発が進められています。また、農業や畜産業、養殖業における病原菌の防除、食品の貯蔵・加工における腐敗の抑制など、各種産業において細菌に起因する経済損失を低減する用途でも利用が検討されています。他方、BALOsを含む捕食性細菌は淡水・海水、土壌、動物体内、下排水処理系など様々な環境中に存在しており、他の細菌を溶菌し、その細菌由来の炭素・エネルギーを周囲に供給することにより、微生物叢の形成において重要な機能をもっているとも指摘されています(4)。
私がこのような特徴を有するBALOsに興味を本格的に持ち始めたのは6年ほど前のことです。私が所属する研究室では、生物機能を活用した環境保全・浄化技術、資源・エネルギー生産技術の開発に取り組んでおり、16S rRNAアンプリコンシーケンスを用いた活性汚泥やウキクサ-微生物共生系などの細菌叢解析を日常的に行っています。たまたま何かの機会に耳にした捕食性細菌に興味をもち始めていた当時、学生から提出されたウキクサ-微生物共生系の細菌叢解析結果を眺めている折にBALOsが優占しているデータを目の当たりにしました。そこで、PCに保存していた様々なサンプルの解析結果を見返してみると、量的には少ないものの、多くのサンプルにBALOsが存在していることに気付きました。この偶然をきっかけとして、活性汚泥やウキクサ-微生物共生系に関する研究に絡めてBALOsを対象とした研究ができないかと思い、2019年度に本格的にBALOsの研究に着手することになりました。
BALOsの研究に着手するにあたり、まず、BALOsの分離に取り掛かりました。BALOsの培養方法には、多くの研究で使用されている重層寒天培地(5)を使用しました。その重層寒天培地は、HMバッファー(HEPES、カルシウム塩、マグネシウム塩で構成)に寒天を1.5%加えて固化させた下層に、餌細菌を高濃度(OD600で10-50程度)で懸濁した寒天0.7%を含むHMバッファーに被検試料(または分離した捕食性細菌)を混合したものを重層して作製します。被検試料中に捕食性細菌が存在すると、餌細菌が溶菌され、溶菌プラークが形成されます(図1)。
BALOsの研究に着手するにあたり、まず、BALOsの分離に取り掛かりました。BALOsの培養方法には、多くの研究で使用されている重層寒天培地(5)を使用しました。その重層寒天培地は、HMバッファー(HEPES、カルシウム塩、マグネシウム塩で構成)に寒天を1.5%加えて固化させた下層に、餌細菌を高濃度(OD600で10-50程度)で懸濁した寒天0.7%を含むHMバッファーに被検試料(または分離した捕食性細菌)を混合したものを重層して作製します。被検試料中に捕食性細菌が存在すると、餌細菌が溶菌され、溶菌プラークが形成されます(図1)。 HI3株の分離時には、餌細菌に大腸菌Escherichia coli HB101、分離源に池の表層水(上述のBALOs優占化が観察されたウキクサ-微生物共生系の構築に使用)を用いました。また、環境中ではBALOsの存在割合が低いことを踏まえ、池水に餌細菌を高濃度で加えて予め培養し、濁度低下が観察されたものをBALOsの分離に用いることにしました。その結果、今回寄託させていただいたHI3株の分離に成功しました。HI3株はBacteriovorax stolpiiの基準株と16S rRNA遺伝子配列が極めて近かったのですが(6)、その後に解析した全ゲノム(7)を用いたAverage Nucleotide Identityは93.3%であり種を識別する閾値(95-96%)以下であったことから、Bacteriovorax sp. HI3と名付けました。

なお、HI3株を液体培地で増殖させる場合、餌細菌を高濃度に加えて共培養し、その濁度低下により目視で増殖状況を判断することができます。また、BALOsは細胞サイズが小さいため(0.25-0.5 × 0.75-1.25 μm;図2)、0.45 μmフィルターを用いるとHI3株のみがフィルターを通過するので、その濾液(実際の作業では濾過を2回行った後の濾液)をHI3株の懸濁液として使用することができます。
HI3株が取得された後、基本的な捕食特性について調査を進めました。プラークアッセイによりグラム陰性菌45株に対する溶菌能を調べたところ、26株を溶菌することが確認され、広範なグラム陰性菌を捕食できることが明らかになりました(6)。また、大腸菌を餌細菌に使用した液体培地中での共培養実験では、大腸菌の減少とともにHI3株の増加と培地中の溶解性有機物濃度の増加が生じ、さらに培養を継続すると、大腸菌が再増加し、溶解性有機物濃度が低下することが観察されました(6)。これらは2種の菌株を用いたシンプルな実験系の結果であるものの、捕食性細菌がその溶菌・捕食能によって環境中の炭素・エネルギーフローに影響し、微生物叢形成に関与していることを示す結果であると考えています。
さらに現在は、HI3株や別に分離した捕食性細菌を環境分野で利用する技術の開拓を目指し、ウキクサ共生細菌群集の改変・制御(8)、下排水処理で発生する余剰汚泥の可溶化促進とそれを介したメタン生成高効率化への捕食性細菌の適用可能性などについて検討を進めています。国内では捕食性細菌はそれほど広く知られている細菌ではありませんが、HI3株の寄託やこの記事を通じて、捕食性細菌の生理・生態機能やバイオテクノロジーにおける有用性を多くの方々に知っていただき、捕食性細菌に関する研究開発コミュニティーが拡大し、研究開発が進展していくことを願っています。
【文献】
(1) Waite et al. (2020). Int. J. Syst. Evol. Microbiol. 70 (11), 5972-6016.
(2) Oren and Garrity (2021). Int. J. Syst. Evol. Microbiol. 71 (10), 005056.
(3) Stolp and Starr (1963). Antonie van Leeuwenhoek 29, 217-248.
(4) Ezzedine et al. (2022). Crit. Rev. Microbiol. 48 (4), 428-449.
(5) Jurkevitch (2012). Curr. Protoc. Microbiol. 26, 7B1.1-7B1.20.
(6) Inoue et al. (2022). Microorganisms 10 (9), 1816.
(7) Inoue et al. (2022). Microbiol. Resour. Announc. 11 (12), e0114622.
(8) Inoue et al. (2023). Microbes Environ. 38 (3), ME23040.
さらに現在は、HI3株や別に分離した捕食性細菌を環境分野で利用する技術の開拓を目指し、ウキクサ共生細菌群集の改変・制御(8)、下排水処理で発生する余剰汚泥の可溶化促進とそれを介したメタン生成高効率化への捕食性細菌の適用可能性などについて検討を進めています。国内では捕食性細菌はそれほど広く知られている細菌ではありませんが、HI3株の寄託やこの記事を通じて、捕食性細菌の生理・生態機能やバイオテクノロジーにおける有用性を多くの方々に知っていただき、捕食性細菌に関する研究開発コミュニティーが拡大し、研究開発が進展していくことを願っています。
【文献】
(1) Waite et al. (2020). Int. J. Syst. Evol. Microbiol. 70 (11), 5972-6016.
(2) Oren and Garrity (2021). Int. J. Syst. Evol. Microbiol. 71 (10), 005056.
(3) Stolp and Starr (1963). Antonie van Leeuwenhoek 29, 217-248.
(4) Ezzedine et al. (2022). Crit. Rev. Microbiol. 48 (4), 428-449.
(5) Jurkevitch (2012). Curr. Protoc. Microbiol. 26, 7B1.1-7B1.20.
(6) Inoue et al. (2022). Microorganisms 10 (9), 1816.
(7) Inoue et al. (2022). Microbiol. Resour. Announc. 11 (12), e0114622.
(8) Inoue et al. (2023). Microbes Environ. 38 (3), ME23040.
4.
DBRP(生物資源データプラットフォーム) ~更新情報のお知らせ~
■山形県工業技術センター有用株を公開(2023年11月8日、2024年1月31日)
山形県工業技術センターが試験・研究により取得した微生物の中から、食品等への応用試験において成績が良好な株を選抜した「山形県工業技術センター有用株」を11月に2株、1月に1株公開しました。3株とも食品由来の乳酸菌です。漬け物の香味改善に用いられた株や、食品等へ粘性、曳糸性(糸引き性)を付与させる性質を持つ株です。 DBRPに登録された山形県工業技術センター有用株の情報は下記URLをご参照ください。
【山形県工業技術センター有用株コレクション情報】
https://www.nite.go.jp/nbrc/dbrp/dataview?dataId=COLL0001000000001
■岐阜大学高等研究院微生物遺伝資源保存センター(GCMR)のGTC株を公開(2024年2月21日)
岐阜大学高等研究院微生物遺伝資源保存センター(GCMR)では、日和見感染菌を含む広汎な病原細菌を維持・提供しています。このたび食中毒の原因となった食品から分離された細菌や臨床分離株を中心に、GCMRが保有する約3,300株の微生物情報をDBRPから公開しました。本コレクションには、病原微生物同定用のDNAチップ作製や、製薬企業での薬剤開発などに用いられた菌株が含まれています。DBRPに登録されたGCMR(GTC株)の情報は下記URLをご参照ください。
【GCMR(GTC株)コレクション情報】
https://www.nite.go.jp/nbrc/dbrp/dataview?dataId=COLL0001100000001
■財団法人発酵研究所で取得されたIFO株(現在はNBRC株)の生理・生化学試験データを公開(2024年1月31日)
NITEバイオテクノロジーセンターで保有するNBRC株には、2002年に公益財団法人発酵研究所(IFO)から移管された菌株が含まれています。これらのうち一部の細菌について、発酵研究所が菌株所有時に調査した表現性状に関する記録と光学顕微鏡画像を電子データ化しDBRPに登録しました。DBRPに登録した情報は下記URLをご参照ください。
【財団法人発酵研究所で取得されたIFO株(現在はNBRC株)の生理・生化学試験データ】
https://www.nite.go.jp/nbrc/dbrp/dataview?dataId=PROJ0000000000003
山形県工業技術センターが試験・研究により取得した微生物の中から、食品等への応用試験において成績が良好な株を選抜した「山形県工業技術センター有用株」を11月に2株、1月に1株公開しました。3株とも食品由来の乳酸菌です。漬け物の香味改善に用いられた株や、食品等へ粘性、曳糸性(糸引き性)を付与させる性質を持つ株です。 DBRPに登録された山形県工業技術センター有用株の情報は下記URLをご参照ください。
【山形県工業技術センター有用株コレクション情報】
https://www.nite.go.jp/nbrc/dbrp/dataview?dataId=COLL0001000000001
■岐阜大学高等研究院微生物遺伝資源保存センター(GCMR)のGTC株を公開(2024年2月21日)
岐阜大学高等研究院微生物遺伝資源保存センター(GCMR)では、日和見感染菌を含む広汎な病原細菌を維持・提供しています。このたび食中毒の原因となった食品から分離された細菌や臨床分離株を中心に、GCMRが保有する約3,300株の微生物情報をDBRPから公開しました。本コレクションには、病原微生物同定用のDNAチップ作製や、製薬企業での薬剤開発などに用いられた菌株が含まれています。DBRPに登録されたGCMR(GTC株)の情報は下記URLをご参照ください。
【GCMR(GTC株)コレクション情報】
https://www.nite.go.jp/nbrc/dbrp/dataview?dataId=COLL0001100000001
■財団法人発酵研究所で取得されたIFO株(現在はNBRC株)の生理・生化学試験データを公開(2024年1月31日)
NITEバイオテクノロジーセンターで保有するNBRC株には、2002年に公益財団法人発酵研究所(IFO)から移管された菌株が含まれています。これらのうち一部の細菌について、発酵研究所が菌株所有時に調査した表現性状に関する記録と光学顕微鏡画像を電子データ化しDBRPに登録しました。DBRPに登録した情報は下記URLをご参照ください。
【財団法人発酵研究所で取得されたIFO株(現在はNBRC株)の生理・生化学試験データ】
https://www.nite.go.jp/nbrc/dbrp/dataview?dataId=PROJ0000000000003
5.
NBRCオンラインカタログの一時停止について
以下の日程においてシステムメンテナンスを行うため、NBRCオンラインカタログがご利用いただけなくなります。ご不便をおかけいたしますが、何卒ご理解いただきますようお願い申し上げます。
【NBRCオンラインカタログ停止予定期間】
2024年3月25日(月)午前10時 ~ 2024年4月1日(月)正午
※メンテナンス日時は予告なく変更される場合があります。
【NBRCオンラインカタログ停止予定期間】
2024年3月25日(月)午前10時 ~ 2024年4月1日(月)正午
※メンテナンス日時は予告なく変更される場合があります。
6.
NBRCが展示、発表等を行うイベントについて
以下のイベントにて講演、発表等を行います。ぜひご参加ください。
日本農芸化学会2024年度東京大会 創立100周年記念大会
日時:2024年3月24日(日)~27日(水)
会場:東京農業大学 世田谷キャンパス (東京都世田谷区桜丘1-1-1)
URL:https://www.jsbba.or.jp/2024/
NITEの参加形態:シンポジウム等での講演(2S07A3p、3S15A3p、4C5a06)
日本農芸化学会2024年度東京大会 創立100周年記念大会
日時:2024年3月24日(日)~27日(水)
会場:東京農業大学 世田谷キャンパス (東京都世田谷区桜丘1-1-1)
URL:https://www.jsbba.or.jp/2024/
NITEの参加形態:シンポジウム等での講演(2S07A3p、3S15A3p、4C5a06)
7.
NITEウェブサイト キッズページリニューアルのお知らせ
3月5日にNITE ウェブサイトのキッズページをリニューアルしました。バイオテクノロジーセンターをはじめNITEの各分野がどんな仕事をしているのかを、アニメ「秘密結社 鷹の爪」の登場キャラクター達と一緒に楽しみながら学べるミニゲームなどがあります。子供だけでなく、大人も楽しめる内容となっていますので、ぜひご覧ください!
【NITEキッズページ】https://www.nite.go.jp/kids/index.html
【NITEキッズページ】https://www.nite.go.jp/kids/index.html
編集後記
春に日本にも影響を及ぼす黄砂ですが、この黄砂に付着することで微生物も大陸を越えて地球規模で移動しているという話を聞きました。もちろん意思をもってやっている訳ではないでしょうが、目に見えないミクロな生き物たちがそうやって生息域を拡大しているのかもしれないと思うと、まだまだ知らないことだらけの世界にワクワクします。(MH)
春に日本にも影響を及ぼす黄砂ですが、この黄砂に付着することで微生物も大陸を越えて地球規模で移動しているという話を聞きました。もちろん意思をもってやっている訳ではないでしょうが、目に見えないミクロな生き物たちがそうやって生息域を拡大しているのかもしれないと思うと、まだまだ知らないことだらけの世界にワクワクします。(MH)
・画像付きのバックナンバーを以下のサイトに掲載しております。受信アドレス変更、受信停止も以下のサイトからお手続きいただけます。
NBRCニュースバックナンバー
・NBRCニュースは配信登録いただいたメールアドレスにお送りしております。万が一間違えて配信されておりましたら、お手数ですが、以下のアドレスにご連絡ください。
・ご質問、転載のご要望など、NBRCニュースについてのお問い合わせは、以下のアドレスにご連絡ください。
・掲載内容を許可なく複製・転載することを禁止します。
・NBRCニュースは偶数月の1日(休日の場合はその前後)に配信します。次号(第87号)は2024年6月3日に配信予定です。
編集・発行
独立行政法人製品評価技術基盤機構(NITE)バイオテクノロジーセンター(NBRC)
NBRCニュース編集局(nbrcnews【@】nite.go.jp)
(メールを送信される際は@前後の【】を取ってご利用ください)
NBRCニュースバックナンバー
・NBRCニュースは配信登録いただいたメールアドレスにお送りしております。万が一間違えて配信されておりましたら、お手数ですが、以下のアドレスにご連絡ください。
・ご質問、転載のご要望など、NBRCニュースについてのお問い合わせは、以下のアドレスにご連絡ください。
・掲載内容を許可なく複製・転載することを禁止します。
・NBRCニュースは偶数月の1日(休日の場合はその前後)に配信します。次号(第87号)は2024年6月3日に配信予定です。
編集・発行
独立行政法人製品評価技術基盤機構(NITE)バイオテクノロジーセンター(NBRC)
NBRCニュース編集局(nbrcnews【@】nite.go.jp)
(メールを送信される際は@前後の【】を取ってご利用ください)
お問い合わせ
-
独立行政法人製品評価技術基盤機構 バイオテクノロジーセンター
生物資源利用促進課
(お問い合わせはできる限りお問い合わせフォームにてお願いします) -
TEL:0438-20-5763
住所:〒292-0818 千葉県木更津市かずさ鎌足2-5-8 地図
お問い合わせフォームへ














